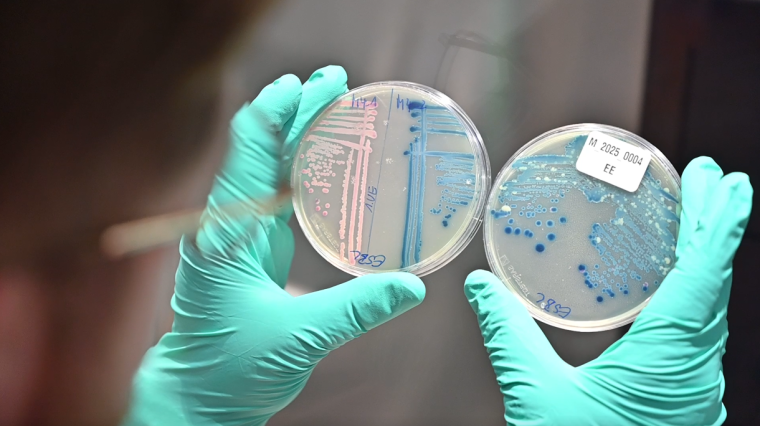
Anzucht multiresistenter E. coli-Bakterien aus Wasserproben. Foto: Josef Wund...

„Wir müssen frühzeitig handeln, 5 nach 12 ist es zu spät“
HIOH-Forscherin Katharina Schaufler spricht im Interview über antibiotikaresistente Keime im Ostseewasser und den dringenden Handlungsbedarf.

Antibiotikaresistenz ist ein weiterhin unterschätztes Problem. Resistente Bakterien finden sich keineswegs nur in Krankenhäusern, sie kommen auch in der natürlichen Umwelt vor. Prof. Katharina Schaufler und ihr Team vom Helmholtz-Institut für One Health (HIOH) in Greifswald – einem Standort des Helmholtz-Zentrums für Infektionsforschung (HZI) – haben an verschiedenen Stellen im Greifswalder Bodden antibiotikaresistente Bakterien im Oberflächenwasser nachgewiesen. Die Probennahme erfolgte unter anderem auch in einem Badebereich, und in einigen Fällen wiesen die detektierten Bakterien sogar Multiresistenzen auf. Die Messwerte sprechen nicht für eine akute Gefährdung von Anwohner*innen und Tourist*innen. Trotzdem, so Schaufler, sollte man die Lage ernst nehmen und nicht erst bei einer Zuspitzung handeln.
Im Zusammenhang mit dem Problem antibiotikaresistenter Bakterien wurde der Begriff der stillen Pandemie geprägt. Was ist damit gemeint?
Katharina Schaufler: Mit „stiller Pandemie“ bezeichnen wir ein globales, schleichendes Gesundheitsrisiko: Immer mehr bakterielle Erreger werden gegen vorhandene Antibiotika unempfindlich, weil diese in Human- und Tiermedizin sowie in der Landwirtschaft übermäßig und teils falsch eingesetzt werden. Unter diesem Selektionsdruck setzen sich resistente Stämme durch und breiten sich in Kliniken, Gemeinschaft und Umwelt aus. Anders als bei COVID-19 geht es hier nicht um einen einzelnen Erreger, dessen Verbreitung sich zuspitzt, sondern es sind viele verschiedene – in diesem Fall – bakterielle Erreger betroffen. Eine akute Krise wie in der Corona-Pandemie besteht derzeit nicht, doch die Belastung mit antibiotikaresistenten Bakterien steigt kontinuierlich an. Ohne konsequente Maßnahmen, zu denen ein verantwortungsvoller Einsatz von Antibiotika – Stichwort Antibiotic Stewardship – ebenso zählt wie Infektionsprävention und One Health-Surveillance, drohen künftig deutlich häufiger schwer behandelbare Infektionen.
Lässt sich der Status quo mit Zahlen untermauern? Wie hoch ist aktuell die Gefahr, dass Menschen infolge von Antibiotikaresistenzen an Infektionen sterben?
Schaufler: Für Deutschland wurde für 2019 geschätzt, dass fast 10.000 Menschen an Infektionen aufgrund von Antibiotikaresistenzen gestorben sind. Todesfälle, bei denen Resistenzen beteiligt waren, wurden auf etwas mehr als 45.000 veranschlagt. Weltweit lagen die Schätzwerte 2019 bei 1,27 bzw. 4,95 Millionen. Diese Zahlen zeigen: Die Mortalität ist bereits heute relevant.
Präventive Maßnahmen fokussieren bislang primär darauf, den – zum Teil unkritischen und inflationären – Einsatz von Antibiotika einzudämmen. Sie betrachten und erforschen das Problem in einem größeren Zusammenhang …
Schaufler: Ja, das HIOH hat es sich zum Ziel gesetzt, Gesundheit im großen Kontext zu denken. Der Einsatz von Antibiotika in der Human- und Tiermedizin findet ja nicht im luftleeren Raum statt. Wir interessieren uns deshalb auch für ökologische Aspekte. Wo und in welchen Mengen sind resistente bzw. multiresistente Keime in der Umwelt nachweisbar? Wie gelangen sie dahin und welche negativen Auswirkungen kann eine solche Umweltbelastung haben? Gibt es Reservoire resistenter Keime in Wildtierpopulationen? Das sind wichtige Fragen, mit denen wir uns beschäftigen.
Antibiotikaresistenzen können sich unter Umständen sehr rasch ausbreiten. Vielleicht können Sie kurz erläutern, wie das genau vor sich geht?
Schaufler: Antibiotikaresistenzen entstehen unter anderem durch spontane Mutationen. Zum Beispiel entwickelt ein Bakterium infolge einer Mutation die Fähigkeit, Antibiotika aus der Zelle herauszupumpen. Wenn sich ein solches Bakterium teilt, vererbt es den Resistenzmechanismus an seine Nachkommen. Das bezeichnet man als vertikalen Gentransfer. In einem antibiotikahaltigen Milieu verschafft die Resistenzmutation den jeweiligen Bakterien einen Selektionsvorteil, und sie werden sich innerhalb der Population ausbreiten.
Im Unterschied dazu findet beim horizontalen Gentransfer ein Austausch von genetischem Material zwischen Bakterien unterschiedlicher Stämme oder Arten statt. Zwischen zwei Bakterienzellen bildet sich dabei ein Pilus aus, über den meist ringförmige DNA-Stücke – Plasmide – mit genetischer Information von einer Zelle auf die andere übertragen werden. Auch Resistenzgene können durch diesen als Konjugation bezeichneten Mechanismus ausgetauscht werden. Weitere Mechanismen des horizontalen Gentransfers, die die Resistenzausbreitung erheblich beschleunigen können, sind Transformation und Transduktion, also die Aufnahme freier DNA bzw. die Übertragung von DNA durch Bakteriophagen.
Kommen wir zurück zu Ihrem One Health-Ansatz. In einer Ende 2024 publizierten Studie hat Ihre Arbeitsgruppe die Belastung von Oberflächenwasser mit multiresistenten Keimen untersucht. Was genau wollten Sie herausfinden? Und wie sind Sie vorgegangen?
Schaufler: Wir wollten herausfinden, ob eine Belastung von Oberflächenwasser mit antibiotikaresistenten Bakterien und Antibiotikarückständen nachweisbar ist. Dazu haben wir im Gebiet des Greifswalder Boddens an drei unterschiedlichen Standorten Proben von Oberflächenwasser entnommen: in der Nähe eines Klärwerks, an einem weiter entfernt liegenden Ostsee-Badestrand und in einem eher abgeschirmten Gebiet auf der Insel Riems. Als Indikatorkeim haben wir Escherichia coli verwendet.
Und was haben Sie herausgefunden?
Schaufler: Wir haben an allen Standorten antibiotikaresistente Escherichia coli gefunden, und zwar teils multiresistente Stämme. Die höchste Anzahl war erwartungsgemäß in der Nähe des Klärwerks nachweisbar, aber auch im weiter weg gelegenen Ostsee-Badebereich und sogar in der Nähe der Insel Riems war das Wasser mit resistenten Bakterien belastet.
Bewegten sich die Bakterienmengen in einer Größenordnung, dass von einer akuten Gesundheitsgefährdung auszugehen ist?
Schaufler: Nein, davon ist aktuell nicht auszugehen. Auf Basis unserer Messwerte und gängiger Leitwerte stufen wir die Wasserqualität mit Blick auf antibiotikaresistente Bakterien derzeit nicht als allzu kritisch ein. Mit größeren Wunden oder ausgeprägter Immunschwäche sollte man allerdings nicht ins Wasser gehen, denn in diesen Fällen ist eine Infektion nicht auszuschließen.
Das entscheidende Ergebnis unserer Studie ist der Tatbestand, dass resistente Bakterien überhaupt in der Umwelt nachweisbar sind. Das heißt, sie sind von der Ursprungsquelle in die Umwelt gelangt. Und noch etwas ist wichtig: Wir haben in den untersuchten Wasserproben resistente Keime gefunden – unabhängig davon, ob Antibiotikarückstände messbar waren oder nicht. Das spricht dafür, dass nicht zwingend ein fortgesetzter direkter Antibiotika-Selektionsdruck erforderlich ist, damit resistente Keime in nachweisbaren Konzentrationen in der Umwelt persistieren.
Sollten angesichts dieser Ergebnisse Konsequenzen gezogen werden?
Schaufler: Eine abschließende Antwort ist derzeit nicht möglich. Wir haben zunächst den Status quo erhoben. Die höheren Konzentrationen multiresistenter Keime in Klärwerknähe legen nahe, die Abwasserreinigung weiter zu optimieren. Üblicherweise arbeiten Kläranlagen mit drei Reinigungsstufen. Zu prüfen ist, ob eine vierte Reinigungsstufe – zum Beispiel durch Ozonierung/Aktivkohle – die Keimzahlen zusätzlich und nachhaltig senken kann.
Von großer Bedeutung – das kann man nicht oft genug betonen – ist eine stärkere Sensibilisierung für die Problematik der Antibiotikaresistenz. Sowohl politische Entscheider*innen als auch die Bevölkerung sollten informiert sein. Nur dann kann Prävention funktionieren, zu der jede*r beitragen kann. Wichtig ist, die Anwendung von Antibiotika auf das erforderliche Minimum zu reduzieren. Sowohl in der Veterinär- als auch der Humanmedizin besteht weiterhin erheblicher Handlungsbedarf. Ein oft zitiertes Beispiel für einen unkritischen Einsatz sind einfache virale Atemwegsinfekte, bei denen Antibiotika nicht helfen.
Ihre Arbeitsgruppe hat bereits Konzepte der Wissenschaftskommunikation entwickelt, um auf das Problem multiresistenter Bakterien in der Natur aufmerksam zu machen. U.a. dafür wurden Sie mit dem Undine Award 2025 ausgezeichnet …
Schaufler: Die Auszeichnung unseres Projekts „Lebensraum Greifswalder Bodden – AMR-Forschung für Gesundheit, Umwelt und Gesellschaft“ mit dem Undine Award 2025 ist Bestätigung und Motivation für uns. Die Auszeichnung, die von der Josef Wund Stiftung für innovative, zukunftsgerichtete Konzepte mit Blick auf die lebenswichtige Ressource Wasser vergeben wird, würdigt unseren Ansatz, aquatische Ökosysteme in Strategien zur Bekämpfung antimikrobieller Resistenzen einzubeziehen. Es ist uns sehr wichtig, unsere Erkenntnisse auch in die Bevölkerung zu kommunizieren. Damit sollte man möglichst früh beginnen, weshalb wir Programme für Schulklassen entwickelt haben. Dabei setzen sich Kinder und Jugendliche aktiv und vor Ort in der Natur mit der Thematik auseinander. Außerdem sollen im nächsten Jahr in der Küstenregion Lehrpfade für Einheimische und Tourist:innen installiert werden
Interview: Ulrike Viegener
Originalpublikation zu E. coli in der Ostsee: Lübcke P, Heiden SE, Homeier-Bachmann T et al: Multidrug-resistant high-risk clonal Escherichia coli lineages occur along an antibiotic residue gradient in the Baltic Sea. npj Clean Water 7, 94 (2024). https://doi.org/10.1038/s41545-024-00394-7
Meist gelesen

Vertrauen als Wettbewerbsvorteil: Europas Weg zur KI im Gesundheitswesen
Vertrauenswürdige KI im Gesundheitswesen ist unverhandelbar. Richtig umgesetzt, sorgen die Ansätze der EU für Sicherheit und Vertrauen.

"Die Quellensuche war eine Herausforderung“
Am Universitätsklinikum Frankfurt am Main trat 2023 eine systemische P. aeruginosa Trinkwasserkontamination auf. Als wahrscheinliche Kontaminationsquelle wurde ein Wasserzähler identifiziert.

Universal Gloving: ein Problem für die Hygiene und die Umwelt
Um Erregerübertragungen und Hautirritationen zu vermeiden sind Einmalhandschuhe indikationsadäquat und nachhaltig zu nutzen.

„Die ePA zwischen Sanktionsdruck und Klinikrealität“
Prof. Dr. Henriette Neumeyer im Interview zur ePA

„Gefahr einer digitalen Zweiklassenmedizin“
Im europäischen Vergleich hinken deutsche Kliniken deutlich hinterher.






